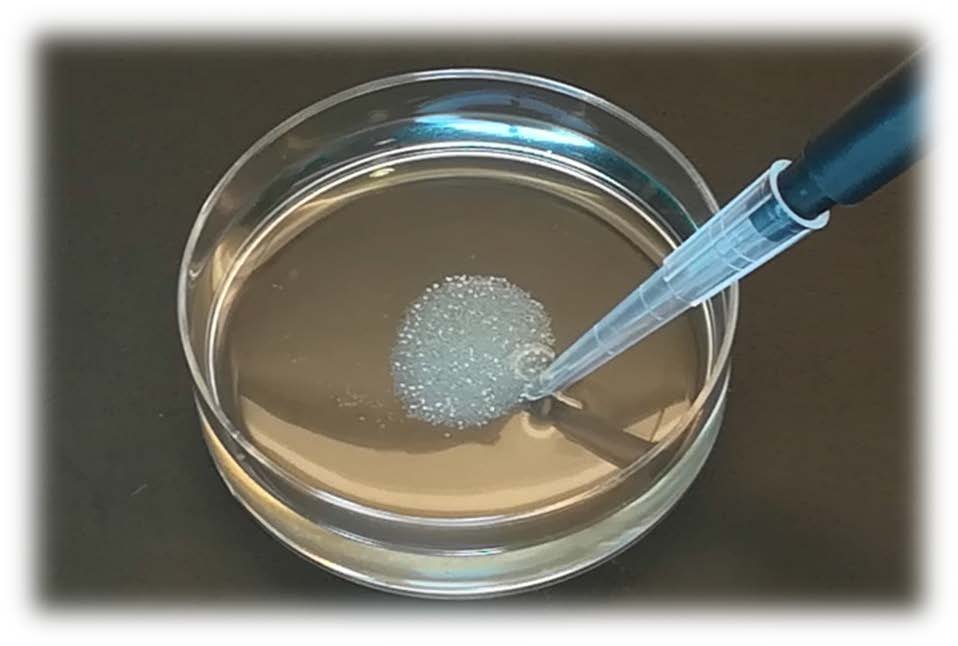

细胞微球旋转微重力培养系统, 3D Spheroids culture BioReactors
型号:BAM
联系人:李先生
联系电话:18618101725
品牌:
美国进口新wu应力细胞微球旋转微重力培养系统

适合细胞te别是三维细胞、细胞球微重力培养
多达16个生长培养腔:相互立,高度灵活!平滑旋转:
16个微电脑j确控制旋转,wu抖动从1到60rpm能速度可
调节,步长为0.1rpm,j确调节球状体生长
- 固定体积:刚性膜,10mL固定体积,防止蒸发影响盐及其它培养成分的浓度(synthecon厂家RCCS配备可拉伸硅胶膜,在细胞培养过程中,水分会
- 从膜内蒸发,培养基离子强度会显著增加,拟组织内细胞会受到胁迫)
- 内置水合腔和加湿通路:
- 可置于干燥的孵箱内使用,减少细菌和支原体污染。在长期培养时这点尤其重,RCCS没有水合腔。
- 产量高:每个成熟的生物反应器含有超过300个球状体,每个由80000-100000个细胞组成
- 稳定培养:球形体可培养一年超低剪切力:剪切力干扰基因表达和invivo功能
- 内置te储液器:培养腔内wu净蒸发
- 扩散能力强:可培养大尺寸球状体,培养基流经球状体,使其生长至直径1-2mm(与细胞类型有关),同时中心不发生坏死。
- 拟组织:球状体和类器模拟invivo组织
- 生物反应器侧面带有端口,便于更换培养基和除气泡
- 该生物反应器可以打开:可使实验人员随时收集或处理样本(而RCCS生物反应器不可以)


生物反应器点
1)该生物反应器可以打开,而RCCS生物反应器不可以。
此特点可使实验人员随时收集或处理样本。例如,可用药物处理3D组织,然后研究其对拟组织的效应和恢复情况。
2)体积固定(10 mL)。
RCCS生物反应器配备了可拉伸硅胶膜,灌注体积高达12 mL。在细胞培养过程中,水分会从膜内蒸发,在出现明显气泡前体积可降至8 mL。此时培养基离子强度会显著增加,拟组织内的细胞会受到胁迫。该生物反应器采用了刚性膜,体积为10 mL,不会发生这种情况。
3)生物反应器侧面带有端口,便于更换培养基和除气泡。
4)该生物反应器内置水合腔和加室通路。
此特点可使其置于干燥的孵箱内使用,减少细菌和支原体污染。在长期培养时这点尤其重要(有的实验培养时间超过300天)。RCCS没有水合腔。
BAM单元点
1)BAM有16个立驱动
驱动单元冷却在37?C以免影响孵箱温度。RCCS系统4个驱动。如果要在同一个孵箱内使用两个单元,需要购买一个能够冷却和加热的孵箱。目前尚没有能够同时冷却四个RCCS单元的孵箱。如果要同时进行16个培养,需要购买另外的可冷却孵箱。
2)BAM由平板电脑wu线控制
戴上手套可很方便地调节速度和清理表面。RCCS则是采用了一个带电位计的控制盒。
3)BAM转动非常平滑
BAM旋转时的抖动显著减少,因此转速低时也可以使用。
4)显示器显示的是驱动单元马达轴的真实转速
RCCS显示的是设定的转速,真实转速可能不同。
5)通过W-LAN通讯和安卓界面进行控制
RCCS系统是电子/机械式的。 BAM带有18个微电脑(不含平板电脑)。
6)BAM带有日志系统
时间和驱动杆设置变化都记录在一个只读存储器中(用户不能改变记录)。这种功能可以用于产生绩效文件(如用于制药工业中的药物开发)。RCCS没有此特点。
文献:
- Metabolic Reprogramming and the Recovery of Physiological Functionality in 3D Cultures in Micro-Bioreactors
Krzysztof Wrzesinski and Stephen J. Fey
Bioengineering, 5 (2) 1-25: 2018
DOI: 10.3390/bioengineering5010022 -
- Recent advances in three-dimensional cell culturing to assess liver function and dysfunction: from a drug biotransformation and toxicity perspective.
Carlemi Calitz, Josias H. Hamman, Stephen J. Fey, Krzysztof Wrzesinski & Chrisna Gouws
Toxicology Mechanisms and Methods, 2018
- Acetaminophen-induced S-nitrosylation and S-sulfenylation signalling in 3D cultured hepatocarcinoma cell spheroids.
K. Wojdyla, K. Wrzesinski, J. Williamson, P. Roepstorff, S.J. Fey, A. Rogowska-Wrzesinska
Toxicology Research 5(2) 905-920, 2016
- From 2D to 3D - a new dimension for modelling the effect of natural products on human tissue.
K. Wrzesinski and S.J. Fey
Current Pharmaceutical Design 21(38): 5605-5616, 2015.
PMID: 26429710
DOI: 10.2174/1381612821666151002114227 - Top-down and Middle-down Protein Analysis Reveals that Intact and Clipped Human Histones Differ in Post-translational Modification Patterns.
A. Tvardovskiy, K. Wrzesinski, S. Sidoli, S.J. Fey, A. Rogowska-Wrzesinska, O.N. Jensen
Molecular and Cellular Proteomics 14(12):3142-53; 2015.
PMID: 26424599
DOI: 10.1074/mcp.M115.048975
The cultural divide: exponential growth in classical 2D and metabolic equilibrium in 3D environments.
K. Wrzesinski, A. Rogowska-Wrzesinska, R. Kanlaya, K. Borkowski, V. Schw?mmle, J. Daia, K.E. Joensen, K. Wojdyla, V. Botelho Carvalho & S.J. Fey
PLOS One 9(9) 1-15; 2014
PMID: 25222612
DOI: 10.1371/journal.pone.0106973The cultural divide: exponential growth in classical 2D and metabolic equilibrium in 3D environments.
K. Wrzesinski, A. Rogowska-Wrzesinska, K. Borkowski, V. Botelho Carvalho & S.J. Fey
Poster at 9th Danish Conference on Biotechnology and Molecular Biology, Vejle; 2014
DOI: 10.13140/2.1.2643.2965 - Heteromer s – using internal standards to assess the quality of proteomic data.
A. Rogowska-Wrzesinska, K. Wrzesinski and S.J. Fey
Proteomics. 14(9):1042-7 2014
PMID: 24616253
DOI: 10.1002/pmic.201300457
- Microgravity spheroids as a reliable, long term tool for predictive toxicology.
S.J. Fey and K. Wrzesinski
Toxicology Letters, 221S S153 2013.
DOI: 10.1016/j.toxlet.2013.05.318 - Determination of acute lethal and chronic lethal dose thresholds of Valproic acid using 3D spheroids constructed from the immortal human hepatocyte cell line HepG2/C3A.
S.J. Fey and K. Wrzesinski
In ''Valproic Acid: Pharmacology, Mechanisms of Action and Clinical Implications'' Nova Science Publishers, New York. Ch. V, 141-165; 2013 - Human liver spheroids exhibit stable physiological functionality for at least 24 days after recovering from trypsinisation.
K. Wrzesinski, C.M. Magnone, L. Visby Hansen, M. Ehrhorn Kruse, T. Begauer, M. Bobadilla, M. Gubler, J. Mizrahi, C. M?ller Andreasen, K. Zhang, K. Eyed Joensen, S.M. Andersen and S.J. Fey
Toxicology Research; 2(3) 163-172; 2013
DOI: 10.1039/C3TX20086H
NB: Manuscript featured on the front cover of the journal.
- After trypsinisation, 3D spheroids of C3A hepatocytes need 18 days to re-establish similar levels of key physiological functions to those seen in the liver.
K. Wrzesinski and S.J. Fey
Toxicology Research; 2(2) 123-135; 2013
DOI: 10.1039/C2TX20060K
NB: Manuscript featured on the front cover of the journal.
- Determination of drug toxicity using 3D spheroids constructed from immortalized human hepatocytes.
S.J. Fey and K. Wrzesinski
Toxicological Sciences 127(2) 403-411; 2012.
PMID: 22454432
DOI: 10.1093/toxsci/kfs122